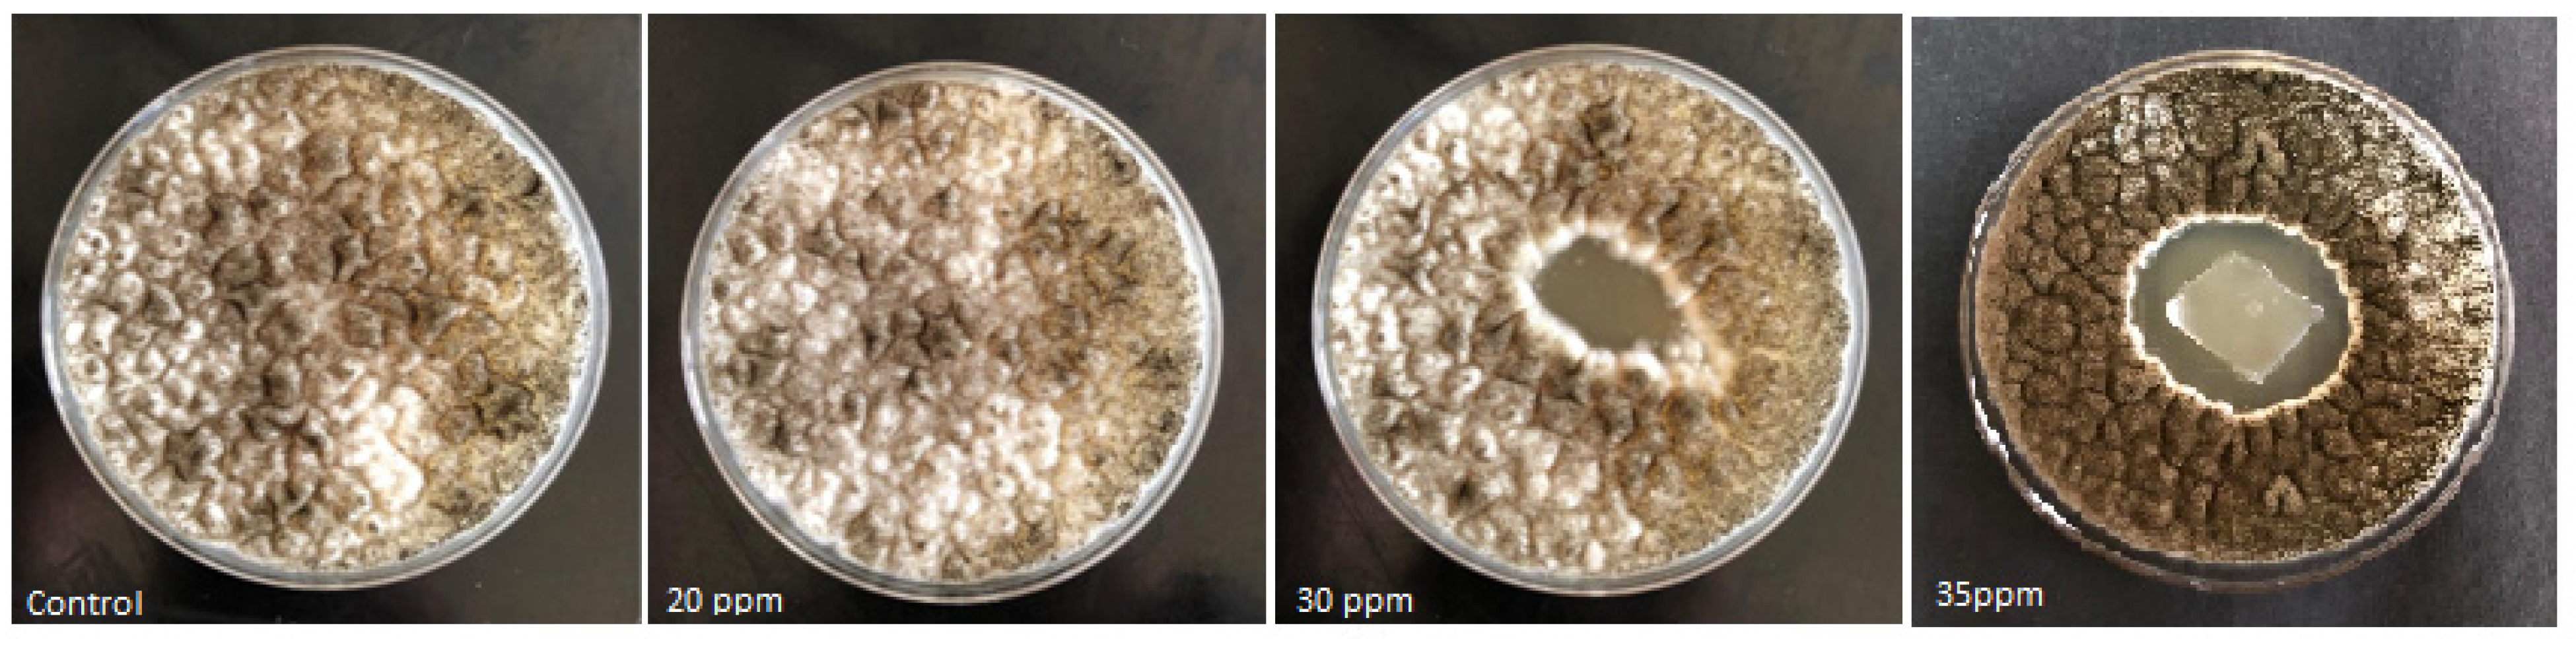
Coatings 12 01204 g003
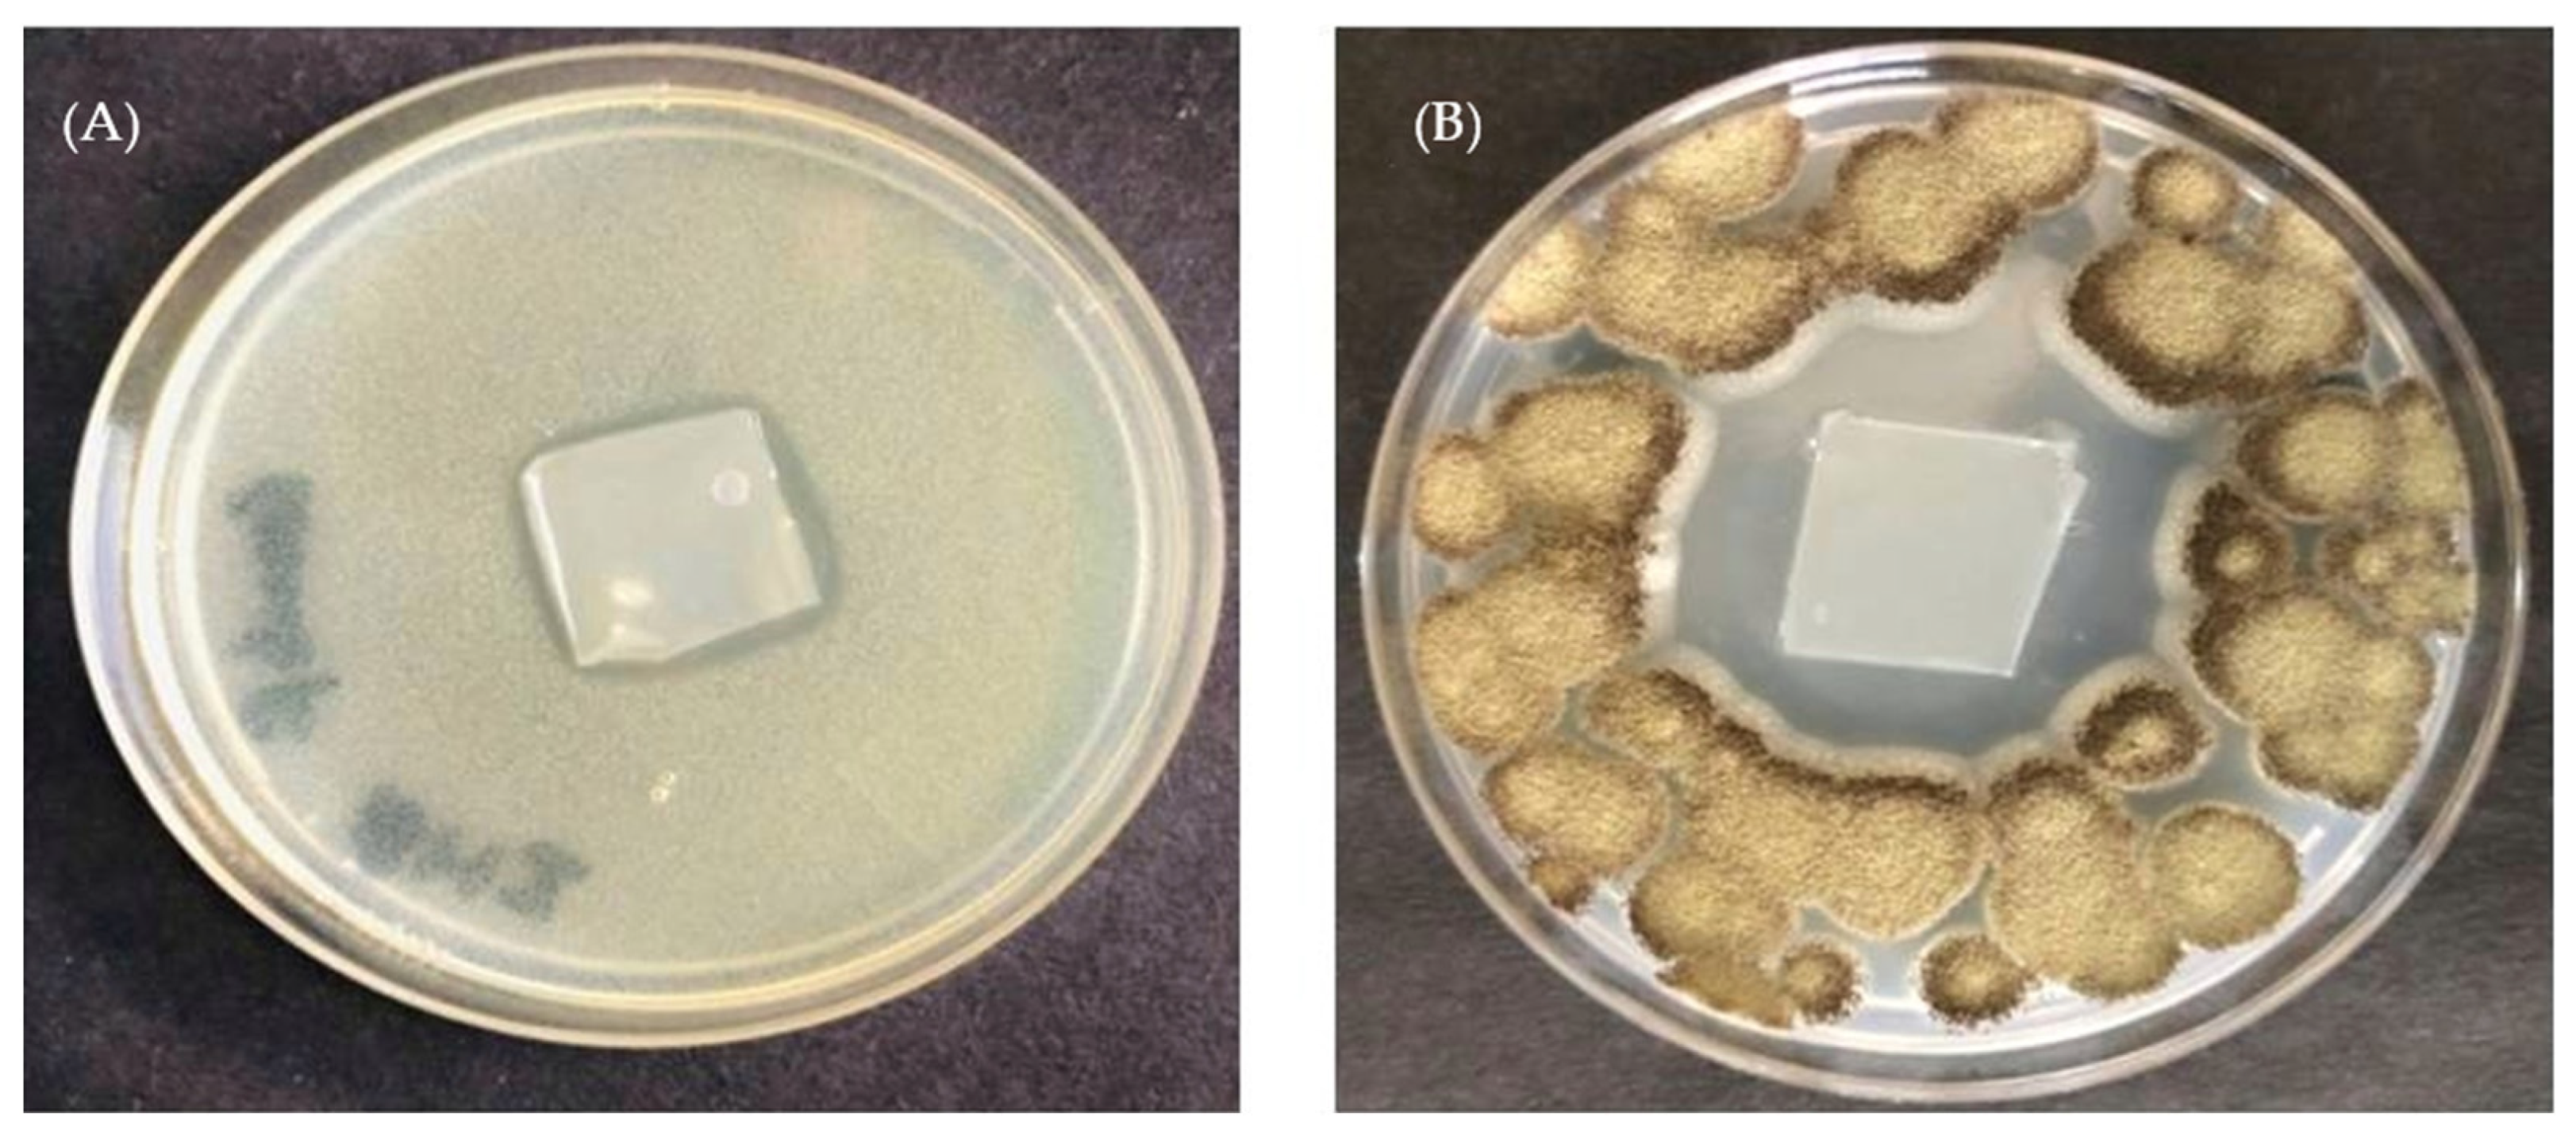
Coatings 12 01204 g004
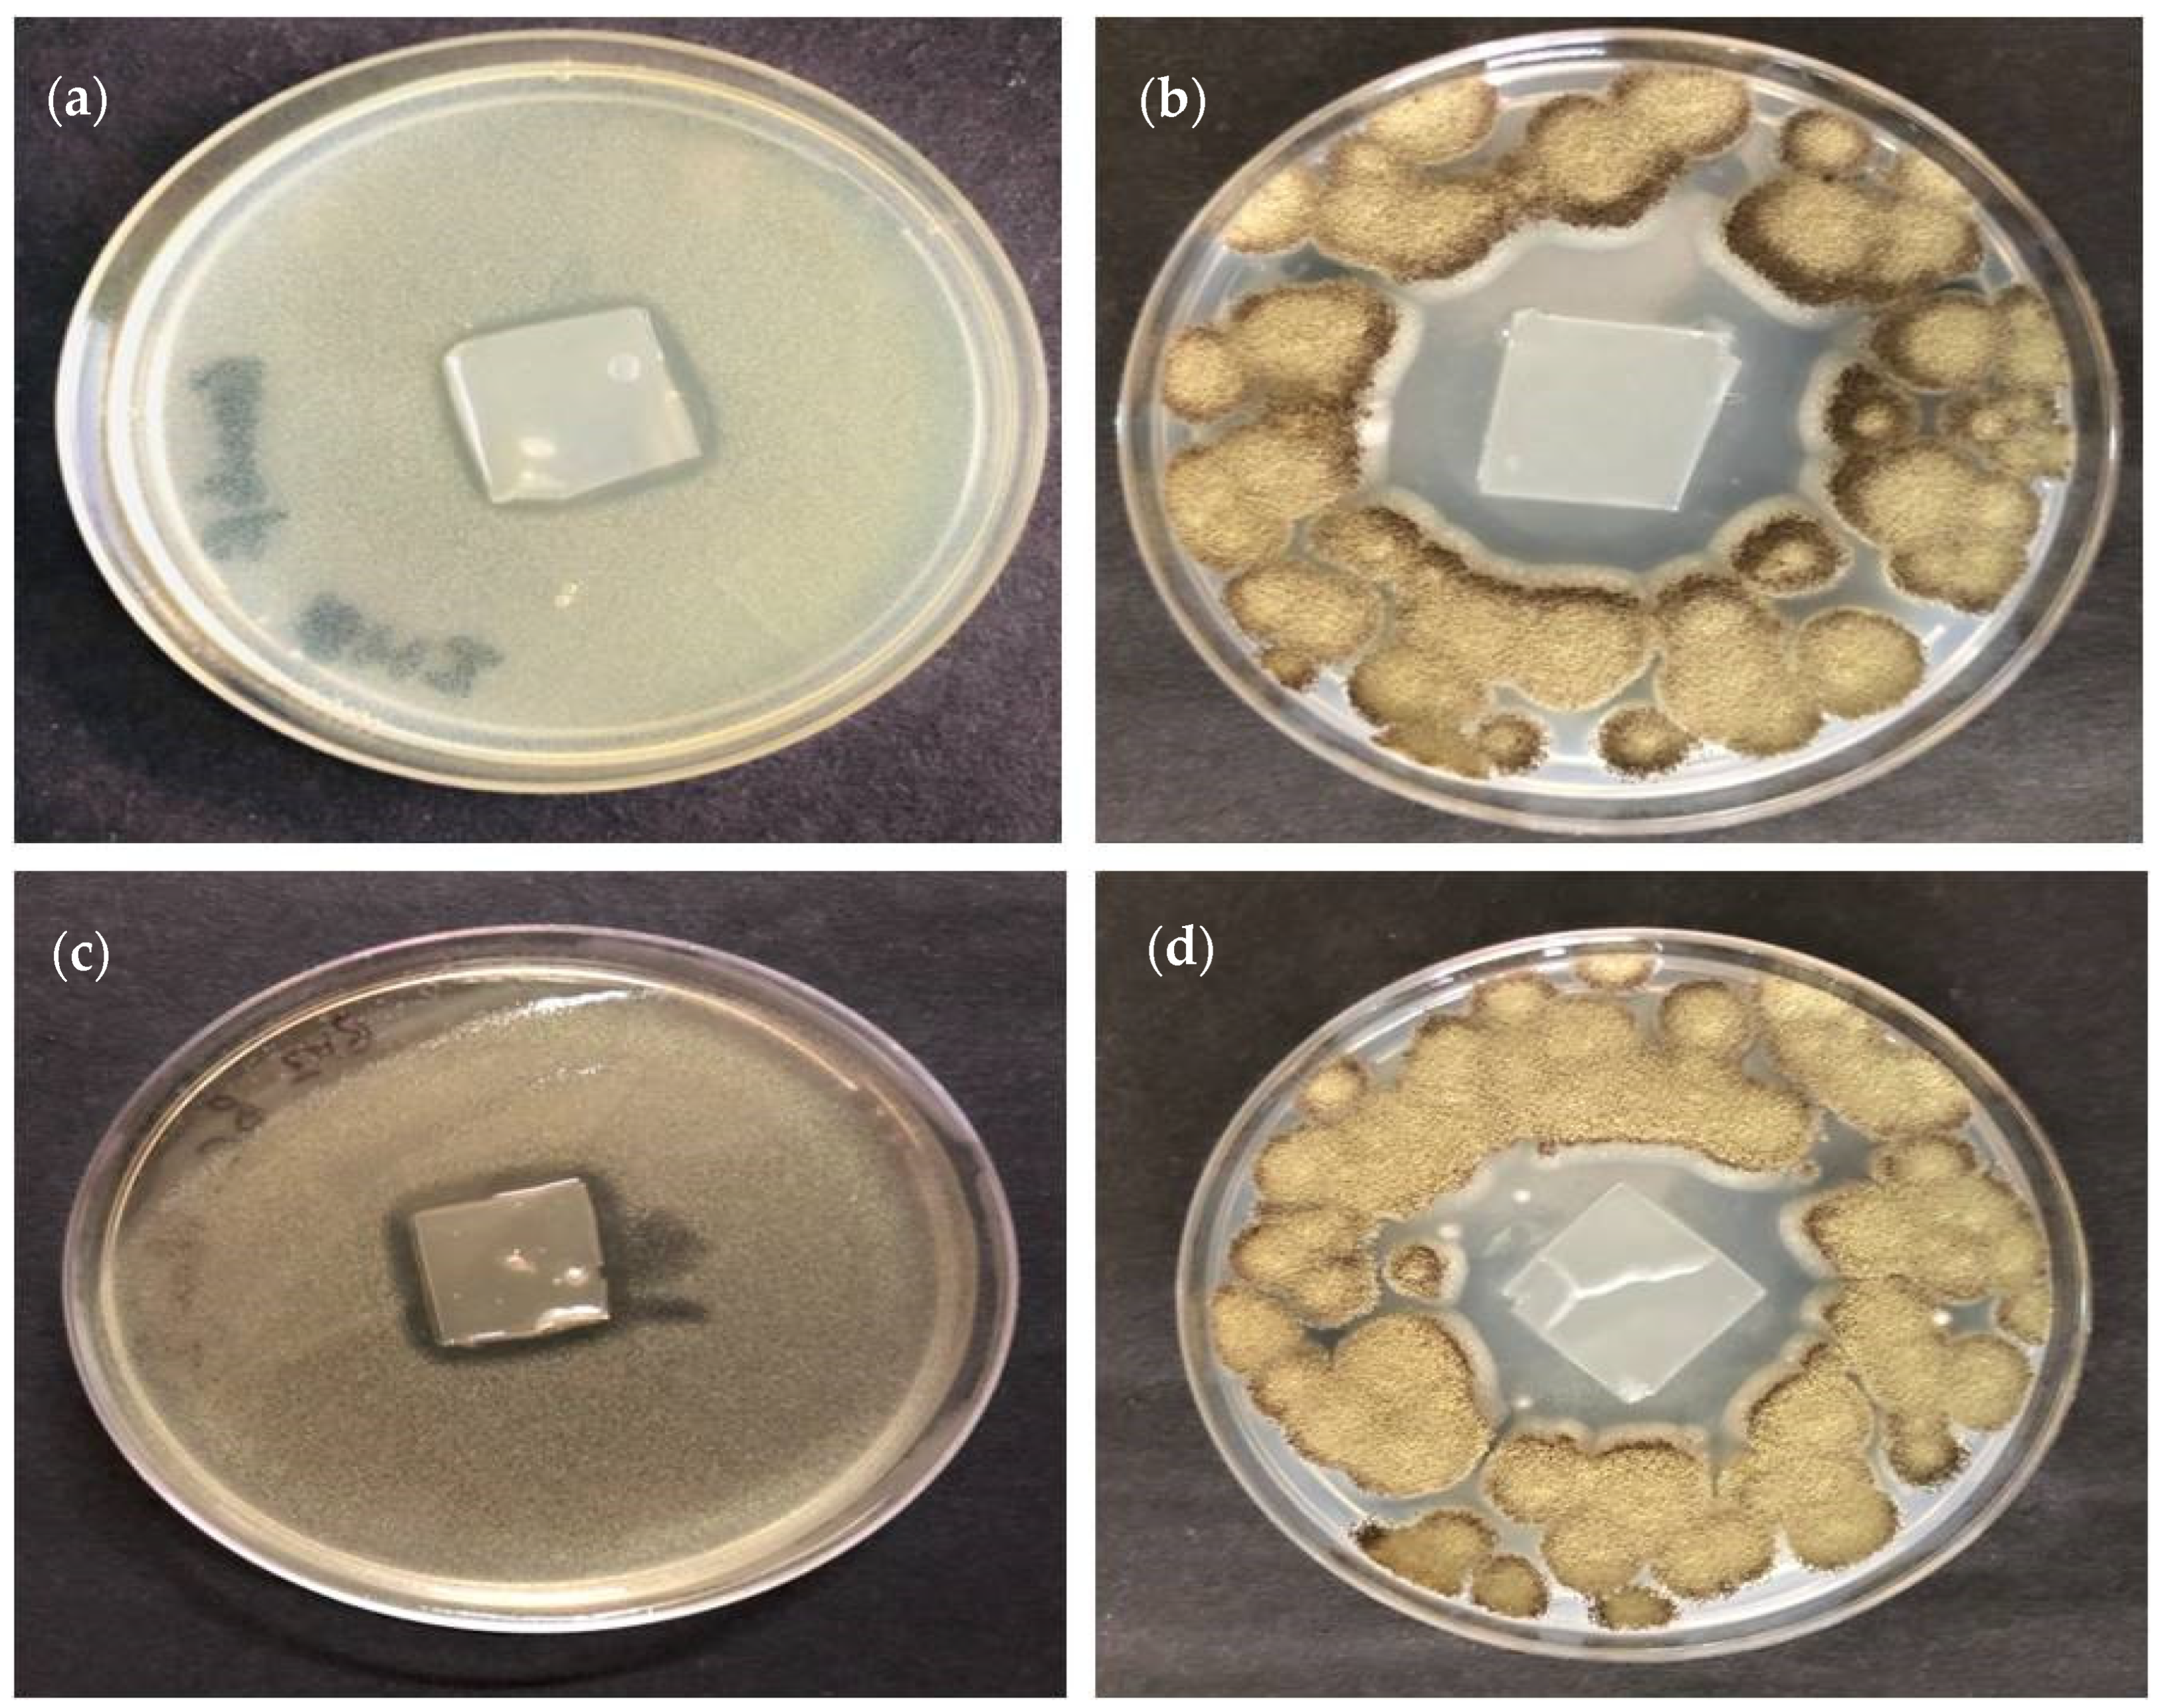
Coatings 12 01204 g005

Integrative Approach of MAP and Active Antimicrobial Packaging for Prolonged Shelf-Life of Composite Bottle Gourd Milk Cake
Abstract
1. Introduction
2. Materials and Methods
2.1. Material
2.2. Fabrication and Assessment of Antimicrobial Films
2.3. Residual Losses Estimation Study
Preparation of Unsterilized and Filter-Sterile Antimicrobial Films
2.4. Manufacturing, Wrapping, and Storage
2.5. Microbiological Investigation
2.6. Sensory Analysis
2.7. Proximate Analysis and Degradative Products
2.8. Statistical Investigation
3. Results and Discussion
3.1. Antimicrobial Activity of Treated Films
3.2. Depletion during Filtration
3.3. Progressive Microbiological Growth
3.4. Changes in Sensory Analysis
3.5. Physiochemical Changes during Storage
4. Conclusions
Author Contributions
Funding
Institutional Review Board Statement
Informed Consent Statement
Data Availability Statement
Conflicts of Interest
References
- Cé, N.; Noreña, C.; Brandelli, A. Antimicrobial activity of chitosan films containing nisin, peptide P34, and natamycin. CyTA J. Food 2012, 10, 21–26. [Google Scholar] [CrossRef]
- Huang, T.; Qian, Y.; Wei, J.; Zhou, C. Polymeric Antimicrobial Food Packaging and Its Applications. Polymers 2019, 11, 560. [Google Scholar] [CrossRef] [PubMed]
- Jain, V.; Rasane, P.; Jha, A.; Sharma, N.; Gautam, A. Effect of modified atmospheric packaging on the shelf life of Kalakand and its influence on microbial, textural, sensory and physico-chemical properties. J. Food Sci. Technol. 2014, 52, 4090–4101. [Google Scholar] [CrossRef] [PubMed]
- Sutariya, H.; Rao, K.J. Effect of Different Packaging Materials on the Physico-Chemical, Microbiological and Sensory Quality of Thirattupal during Storage. Int. J. Curr. Microbiol. Appl. Sci. 2017, 6, 1529–1539. [Google Scholar] [CrossRef]
- Biji, K.B.; Ravishankar, C.N.; Mohan, C.O.; Gopal, T.K.S. Smart packaging systems for food applications: A review. J. Food Sci. Technol. 2015, 52, 6125–6135. [Google Scholar] [CrossRef]
- Basch, C.Y.; Jagus, R.J.; Flores, S.K. Physical and Antimicrobial Properties of Tapioca Starch-HPMC Edible Films Incorporated with Nisin and/or Potassium Sorbate. Food Bioprocess Technol. 2012, 6, 2419–2428. [Google Scholar] [CrossRef]
- Flores, S.; Conte, A.; Campos, C.; Gerschenson, L.; Del Nobile, M. Mass transport properties of tapioca-based active edible films. J. Food Eng. 2007, 81, 580–586. [Google Scholar] [CrossRef]
- Sung, S.-Y.; Sin, L.T.; Tee, T.-T.; Bee, S.-T.; Rahmat, A.; Rahman, W.; Tan, A.-C.; Vikhraman, M. Antimicrobial agents for food packaging applications. Trends Food Sci. Technol. 2013, 33, 110–123. [Google Scholar] [CrossRef]
- Bhatia, S.; Bharti, A. Evaluating the antimicrobial activity of Nisin, Lysozyme and Ethylenediaminetetraacetate incorporated in starch based active food packaging film. J. Food Sci. Technol. 2015, 52, 3504–3512. [Google Scholar] [CrossRef]
- Cao-Hoang, L.; Grégoire, L.; Chaine, A.; Waché, Y. Importance and efficiency of in-depth antimicrobial activity for the control of listeria development with nisin-incorporated sodium caseinate films. Food Control. 2010, 21, 1227–1233. [Google Scholar] [CrossRef]
- Chollet, E.; Sebti, I.; Martial-Gros, A.; Degraeve, P. Nisin preliminary study as a potential preservative for sliced ripened cheese: NaCl, fat and enzymes influence on nisin concentration and its antimicrobial activity. Food Control. 2008, 19, 982–989. [Google Scholar] [CrossRef]
- Hameed, K.G.A. Fungal diversity in different types of cheese and the effect of natamycin on their survival during Feta cheese manufacture and storage. J. Adv. Veter- Anim. Res. 2016, 3, 214. [Google Scholar] [CrossRef]
- Anean, H.E.D.A.; El Din, H.; Anean, A.; El Aunousy, N.; Ghfour, S.A.; Bader, S.E. Effect of Modified Atmosphere Packaging and Edible Films on the Quality of Carp Fish Patties. J. Nutr. Health Food Eng. 2018, 8, 1. [Google Scholar] [CrossRef]
- Singh, N.; Chawla, R.; Sivakumar, S. Studying the Properties of Edible Packaging for Milk Cake and its Effect during Refrigerated Storage. J. Packag. Technol. Res. 2020, 5, 29–40. [Google Scholar] [CrossRef]
- Chawla, R.; Sivakumar, S.; Kaur, H.; Mishra, S.K. Effect of starch based edible antimicrobial films and modified atmospheric packaging (MAP) on extended life of composite sweetmeat. Carbohydr. Polym. Technol. Appl. 2021, 2, 100055. [Google Scholar] [CrossRef]
- Chawla, R.; Sivakumar, S.; Mishra, S.K.; Kaur, H.; Anurag, R.K. Modified atmosphere packaging for milk cake: Assessment of ideal gas composition for extending shelf life. Br. Food J. 2021, 123, 2893–2906. [Google Scholar] [CrossRef]
- Bandyopadhyay, M.; Mukherjee, R.S.; Chakraborty, R.; Raychaudhuri, U. A Survey on Formulations and Process Techniques of Some Special Indian Traditional Sweets and Herbal Sweets. Indian Dairym. 2006, 58, 23–35. [Google Scholar]
- Shete, S.M.; Pawar, B.K.; Choudhari, D.M.; Kamble, D.K. Quality of Different Types of Burfi Sold in Ahmednagar Market. Asian J. Dairy Food Res. 2015, 31, 5–8. [Google Scholar]
- Anurag, C.R.; Khatkar, S.K.; Bhaskar, D. Effect of Temperature on Physico-Chemical and Sensory Attributes of Bottle Gourd Burfi. Indian J. Dairy Sci. 2017, 70, 391–397. [Google Scholar]
- Anurag, A.; Chawla, R. Studies on preparation of composite dairy food-bottle gourd burfi. Asian J. Dairy Food Res. 2016, 35, 196–200. [Google Scholar] [CrossRef]
- Wehr, H.M.; Frank, J.F. Standard Methods for the Examination of Dairy Products; American Public Health Association: Washington, DC, USA, 2004. [Google Scholar]
- Issar, K.; Sharma, P.; Gupta, A. Utilization of Apple Pomace in the Preparation of Fiber-Enriched Acidophilus Yoghurt. J. Food Process. Preserv. 2016, 41, e13098. [Google Scholar] [CrossRef]
- Chawla, R.; Sivakumar, S.; Kaur, H. Antimicrobial Edible Films in Food Packaging: Current Scenario and Recent Nanotechnological Advancements—A Review. Carbohydr. Polym. Technol. Appl. 2021, 2, 100024. [Google Scholar] [CrossRef]
- Resa, C.P.O.; Gerschenson, L.N.; Jagus, R.J. Starch edible film supporting natamycin and nisin for improving microbiological stability of refrigerated argentinian Port Salut cheese. Food Control 2016, 59, 737–742. [Google Scholar] [CrossRef]
- Pintado, C.M.; Ferreira, M.A.; Sousa, I. Control of pathogenic and spoilage microorganisms from cheese surface by whey protein films containing malic acid, nisin and natamycin. Food Control 2010, 21, 240–246. [Google Scholar] [CrossRef]
- Resa, C.P.O.; Jagus, R.J.; Gerschenson, L.N. Natamycin efficiency for controlling yeast growth in models systems and on cheese surfaces. Food Control 2014, 35, 101–108. [Google Scholar] [CrossRef]
- Berti, S.; Flores, S.; Jagus, R.J. Improvement of the microbiological quality of Argentinian Port Salut cheese by applying starch-based films and coatings reinforced with rice bran and containing natural antimicrobials. J. Food Process. Preserv. 2020, 44. [Google Scholar] [CrossRef]
- FSSAI Food Safety and Standards Authority of India (FSSAI). 2011. Available online: https://www.fssai.gov.in/dam/Compendium_Food_Additives_Regulations_29_03_2019.pdf (accessed on 4 May 2019).
- Chawla, R.; Kumar, A.; Girdhari, S.; Patil, R. Shelf Life Enhancement of Functional Doda Burfi (Indian Milk Cake) With. Int. J. Res. Sci. Technol. 2015, 5, 26–40. [Google Scholar]
- Aggarwal, A.; Seth, R.; Gandhi, K.; Wangdare, S. Physico-chemical properties of Khoa prepared from lactose hydrolyzed buffalo milk. J. Food Sci. Technol. 2019, 56, 3067–3076. [Google Scholar] [CrossRef]
- Mishra, B.B.; Pandey, R.K.; Patel, A.S.; Pradhan, R.C. Modified Atmospheric Packaging (MAP) of Trichosanthes Dioica (Parwal) Sweet and Effect of Storage Temperature on the Physicochemical, Microbial and Sensory Characteristics. Curr. Res. Nutr. Food Sci. J. 2019, 7, 708–724. [Google Scholar] [CrossRef]
- Jha, A.; Kumar, A.; Jain, P.; Gautam, A.K.; Rasane, P. Effect of modified atmosphere packaging on the shelf life of lal peda. J. Food Sci. Technol. 2013, 52, 1068–1074. [Google Scholar] [CrossRef]
- Kalem, I.K.; Bhat, Z.; Kumar, S.; Noor, S.; Desai, A. The effects of bioactive edible film containing Terminalia arjuna on the stability of some quality attributes of chevon sausages. Meat Sci. 2018, 140, 38–43. [Google Scholar] [CrossRef] [PubMed]
- Noor, S.; Bhat, Z.; Kumar, S.; Mudiyanselage, R.J. Preservative effect of Asparagus racemosus: A novel additive for bioactive edible films for improved lipid oxidative stability and storage quality of meat products. Meat Sci. 2018, 139, 207–212. [Google Scholar] [CrossRef] [PubMed]
- Chowdhury, T.; Chattopadhyay, S.K.; Saha, N.C. Modified Atmosphere Packaging (MAP) and the Effect of Chemical Preservative to Enhance Shelf Life of Khoa (Heat Desiccated Milk Product). J. Packag. Technol. Res. 2017, 1, 25–31. [Google Scholar] [CrossRef]
- Chawla, R.; Patil, G.R.; Singh, A.K. Effect of temperature on sensory and textural attributes of functional doda burfi (Indian milk cake). J. Food Sci. Technol. 2013, 52, 586–591. [Google Scholar] [CrossRef]
- Mahalingaiah, L.; Venkateshaiah, B.V.; Kulkarni, S.; Rao, K.J. Study on the effect of packaging materials on the physico-chemical, microbiological and sensory quality of kunda. J. Food Sci. Technol. 2011, 51, 1000–1005. [Google Scholar] [CrossRef]
- Chatli, M.K.; Kaura, S.; Jairath, M.; Mehta, N.; Kumar, P.; Sahoo, J. Storage stability of raw chevon chunks packaged in composite, bioactive films at refrigeration temperature. Anim. Prod. Sci. 2014, 54, 1328–1332. [Google Scholar] [CrossRef]
- Londhe, G.; Pal, D.; Raju, P.N. Effect of packaging techniques on shelf life of brown peda, a milk-based confection. LWT 2012, 47, 117–125. [Google Scholar] [CrossRef]
- Mushtaq, M.; Gani, A.; Gani, A.; Punoo, H.A.; Masoodi, F. Use of pomegranate peel extract incorporated zein film with improved properties for prolonged shelf life of fresh Himalayan cheese (Kalari/kradi). Innov. Food Sci. Emerg. Technol. 2018, 48, 25–32. [Google Scholar] [CrossRef]
- Ghayal, G.; Jha, A.; Kumar, A.; Gautam, A.K.; Rasane, P. Effect of modified atmospheric packaging on chemical and microbial changes in dietetic rabri during storage. J. Food Sci. Technol. 2013, 52, 1825–1829. [Google Scholar] [CrossRef]
- Choudhary, S.; Arora, S.; Kumari, A.; Narwal, V.; Singh, A.K. Effect of quality of milk on physico-chemical characteristics of buffalo milk concentrate (khoa) during storage. J. Food Sci. Technol. 2019, 56, 1302–1315. [Google Scholar] [CrossRef]
- Kavas, G.; Kavas, N.; Saygili, D. The Effects of Thyme and Clove Essential Oil Fortified Edible Films on the Physical, Chemical and Microbiological Characteristics of Kashar Cheese. J. Food Qual. 2015, 38, 405–412. [Google Scholar] [CrossRef]
- Barukčić, I.; Ščetar, M.; Marasović, I.; Jakopović, K.L.; Galić, K.; Božanić, R. Evaluation of quality parameters and shelf life of fresh cheese packed under modified atmosphere. J. Food Sci. Technol. 2020, 57, 2722–2731. [Google Scholar] [CrossRef] [PubMed]
- Gaikwad, S.; Hembade, A. Effect of Storage Temperature on Microbiological Quality of Standardized Cow Milk Ujani Basundi. Int. J. Dairy Sci. 2012, 7, 34–42. [Google Scholar] [CrossRef][Green Version]
- Bajwa, U.; Gupta, M. Quality Evaluation of Carrot-Milk Cake Marketed in Ludhiana. J. Food Sci. Technol. 2007, 44, 70–73. [Google Scholar]
- Durrani, A.M.; Srivastava, P.K.; Verma, S. Development and quality evaluation of honey based carrot candy. J. Food Sci. Technol. 2011, 48, 502–505. [Google Scholar] [CrossRef]
- Karunamay, S.; Badhe, S.R.; Shulka, V. Comparative study of essential oil of clove and oregano treated edible film in extending shelf life of paneer. Pharma Innov. 2020, 9, 312–316. [Google Scholar] [CrossRef]
- Yang, S.-Y.; Cao, L.; Kim, H.; Beak, S.-E.; Bin Song, K. Utilization of Foxtail Millet Starch Film Incorporated with Clove Leaf Oil for the Packaging of Queso Blanco Cheese as a Model Food. Starch Staerke 2017, 70, 3–4. [Google Scholar] [CrossRef]

| Attributes | Storage Period (Days) | |||||
|---|---|---|---|---|---|---|
| 0 | 7 | 14 | 21 | 28 | 35 | |
| pH | ||||||
| Control | 6.603 ± 0.009 Aa | 6.563 ± 0.009 Ab | 6.507 ± 0.009 Ac | 6.310 ± 0.012 Bd | - | - |
| NANIF | 6.603 ± 0.009 Aa | 6.573 ± 0.012 Aab | 6.533 ± 0.009 Ab | 6.400 ± 0.015 Ac | 6.273 ± 0.020 Ad | 6.093 ± 0.022 Ae |
| Titratable Acidity (%LA) | ||||||
| Control | 0.084 ± 0.003 Ac | 0.238 ± 0.030 Ab | 0.293 ± 0.018 Ab | 0.380 ± 0.022 Aa | - | - |
| NANIF | 0.084 ± 0.003 Ac | 0.223 ± 0.026 Ab | 0.263 ± 0.016 Ab | 0.283 ± 0.033 Ab | 0.318 ± 0.048 Aab | 0.383 ± 0.027 Aa |
| Moisture (%) | ||||||
| Control | 24.95 ± 0.22 Aa | 24.06 ± 0.18 Ab | 22.97 ± 0.26 Ac | 21.40 ± 0.12 Bd | - | - |
| NANIF | 24.95 ± 0.22 Aa | 24.35 ± 0.27 Ab | 23.53 ± 0.15 Ac | 22.09 ± 0.10 Ad | 21.52 ± 0.22 Ad | 20.90 ± 0.10 Ae |
| Ash (%) | ||||||
| Control | 1.24 ± 0.01 Ab | 1.41 ± 0.05 Ab | 1.54 ± 0.02 Aa | 1.62 ± 0.01 Aa | - | - |
| NANIF | 1.24 ± 0.01 Ab | 1.26 ± 0.02 Ab | 1.32 ± 0.01 Bb | 1.33 ± 0.01 Bb | 1.56 ± 0.02 Aa | 1.61 ± 0.01 Aa |
| Total sugars (%) | ||||||
| Control | 26.35 ± 0.13 Ac | 27.40 ± 0.26 Ab | 27.90 ± 0.42 Ab | 29.23 ± 0.42 Aa | - | - |
| NANIF | 26.35 ± 0.13 Ae | 26.56 ± 0.26 Ade | 26.98 ± 0.11 Ad | 27.70 ± 0.08 Bc | 28.67 ± 0.22 Ab | 30.14 ± 0.21 Aa |
| Reducing sugars (%) | ||||||
| Control | 13.13 ± 0.40 Ac | 13.98 ± 0.29 Ac | 15.29 ± 0.19 Ab | 17.29 ± 0.31 Aa | - | - |
| NANIF | 13.13 ± 0.40 Ad | 13.46 ± 0.21 Acd | 14.21 ± 0.15 Bc | 15.72 ± 0.28 Bb | 16.63 ± 0.25 Ab | 17.89 ± 0.55 Aa |
| Tyrosine value (mg/100g) | ||||||
| Control | 0.056 ± 0.004 Ad | 0.113 ± 0.001 Ac | 0.123 ± 0.002 Ab | 0.136 ± 0.002 Aa | - | - |
| NANIF | 0.056 ± 0.004 Af | 0.098 ± 0.001Be | 0.106 ± 0.002 Bd | 0.115 ± 0.002 Bc | 0.126 ± 0.002 Ab | 0.133 ± 0.002 Aa |
| Free Fatty Acids (FFA) value (µeq/g) | ||||||
| Control | 0.265 ± 0.021 Ac | 0.504 ± 0.079 Ab | 0.548 ± 0.076 Ab | 0.878 ± 0.090 Aa | - | - |
| NANIF | 0.265 ± 0.021 Ad | 0.298 ± 0.083 Ad | 0.468 ± 0.048 Ac | 0.735 ± 0.046 Ab | 0.828 ± 0.079 Aab | 0.982 ± 0.003 Aa |
| Hydroxyl methyl furfural (HMF) value (µmoles/100g) | ||||||
| Control | 10.13 ± 0.19 Ad | 13.34 ± 0.23 Ac | 14.68 ± 0.13 Ab | 15.96 ± 0.30 Aa | - | - |
| NANIF | 10.13 ± 0.19 Af | 12.94 ± 0.12 Ae | 13.70 ± 0.13 Bd | 14.39 ± 0.17 Bc | 15.04 ± 0.12 Ab | 16.38 ± 0.20 Aa |
| Thio-barbituric acid (TBA) value (Absorbance) | ||||||
| Control | 0.062 ± 0.005 Ac | 0.114 ± 0.004 Ab | 0.170 ± 0.009 Aa | 0.187 ± 0.005 Aa | - | - |
| NANIF | 0.062 ± 0.005 Ae | 0.092 ± 0.008 Bd | 0.123 ± 0.005 Bc | 0.146 ± 0.007 Bb | 0.155 ± 0.005 Ab | 0.186 ± 0.005 Aa |
Publisher’s Note: MDPI stays neutral with regard to jurisdictional claims in published maps and institutional affiliations. |
© 2022 by the authors. Licensee MDPI, Basel, Switzerland. This article is an open access article distributed under the terms and conditions of the Creative Commons Attribution (CC BY) license (https://creativecommons.org/licenses/by/4.0/).
Share and Cite
Chawla, R.; Shanmugam, S.; Bedi, J.S.; Selvamuthukumaran; Yadav, D.N.; Anurag, R. Integrative Approach of MAP and Active Antimicrobial Packaging for Prolonged Shelf-Life of Composite Bottle Gourd Milk Cake. Coatings 2022, 12, 1204. https://doi.org/10.3390/coatings12081204
Chawla R, Shanmugam S, Bedi JS, Selvamuthukumaran, Yadav DN, Anurag R. Integrative Approach of MAP and Active Antimicrobial Packaging for Prolonged Shelf-Life of Composite Bottle Gourd Milk Cake. Coatings. 2022; 12(8):1204. https://doi.org/10.3390/coatings12081204
Chicago/Turabian StyleChawla, Rekha, Sivakumar Shanmugam, Jasbir Singh Bedi, Selvamuthukumaran, Deep N. Yadav, and Rahul Anurag. 2022. "Integrative Approach of MAP and Active Antimicrobial Packaging for Prolonged Shelf-Life of Composite Bottle Gourd Milk Cake" Coatings 12, no. 8: 1204. https://doi.org/10.3390/coatings12081204
APA StyleChawla, R., Shanmugam, S., Bedi, J. S., Selvamuthukumaran, Yadav, D. N., & Anurag, R. (2022). Integrative Approach of MAP and Active Antimicrobial Packaging for Prolonged Shelf-Life of Composite Bottle Gourd Milk Cake. Coatings, 12(8), 1204. https://doi.org/10.3390/coatings12081204

